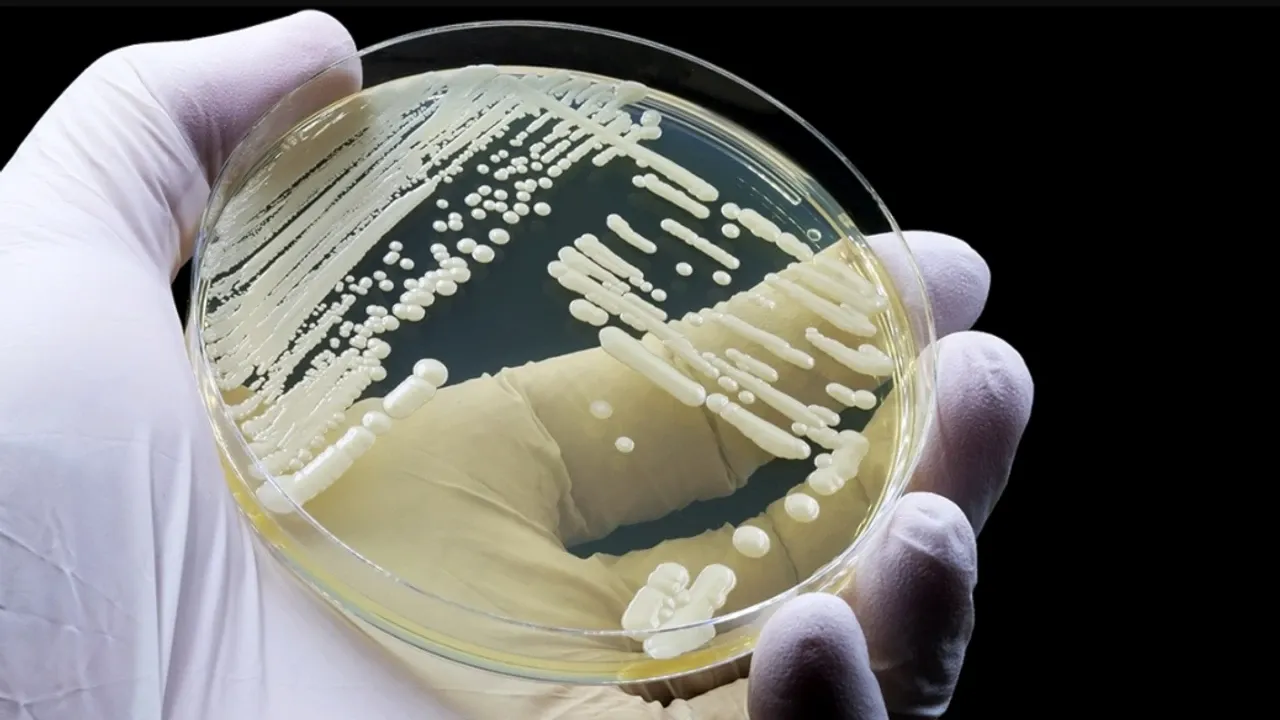

Birleşik Arap Emirlikleri’nin Ras El-Hayme kentinde yaşayan 34 yaşındaki bir erkek, ciddi kafa travması sonrası ameliyat edildi. Ancak iyileşemeyen hastada yapılan testlerde beynin, Candida auris mantarıyla enfekte olduğu belirlendi. Uzmanlar, mantarın kazadan kaynaklanan açık yaralardan beyne ulaşmış olabileceğini değerlendirdi.
İlaç direnci endişesi artıyor
Tedavi sürecini yürüten doktorlar, tarım ve sağlık sektörlerinde mantar ilaçlarının aşırı kullanımının Candida auris’in ilaçlara karşı direnç geliştirmesine yol açtığını ifade etti. Dünya Sağlık Örgütü, bu mantarı dünyadaki en ölümcül 19 mantar türünden biri olarak sınıflandırıyor. Enfekte olan her üç kişiden birinin hayatını kaybettiği bildiriliyor.
Hastane yüzeylerinde hayatta kalabiliyor
Candida auris, hastane yüzeylerinde ve insan cildinde uzun süre yaşayabiliyor. Dezenfektanlara ve ilaçlara karşı dirençli olması nedeniyle beyin dışında omurilik, kemikler, karın boşluğu, kulak, akciğer ve idrar yollarına da yayılabiliyor.
Yoğun tedavi ile hayatta kaldı
Daily Mail, ameliyat geçiren adamın onlarca mantar önleyici enjeksiyon ve damla ile 11 gün süren yoğun bir antifungal tedavi sonucunda hayatta kaldığını yazdı.